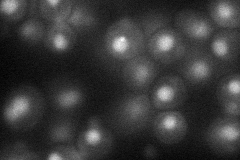
YOR144C
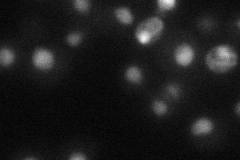
YOR144C

View description
Protein required for S phase progression and telomere homeostasis, forms an alternative replication factor C complex important for DNA replication and genome integrity; involved in homologous recombination-mediated DNA repair
Localization:
Intensity:
Fold change:
Significance:
-
C’ GFP library in SD

nucleus19.27 -
N' NOP1pr-GFP in SD
nucleus38.9065 -
N' TEF2pr-mCherry in SD
nucleus19.6355 -
N' NATIVEpr-GFP in SD

nucleus19.197 -
N' TEF2pr-VC and Cyto-VN in SD

punctate,nucleus31.0102 -
C’ GFP library in SD+DTT

nucleus20.181.04No -
C’ GFP library in SD+H2O2

nucleus22.111.14No -
C’ GFP library in Starvation Media

nucleusN/AN/AYes -
C’ GFP library on the background of Pup2-DaMP

nucleus -
C’ GFP library on the background of CCT mutant

nucleus20.8311.08052No
